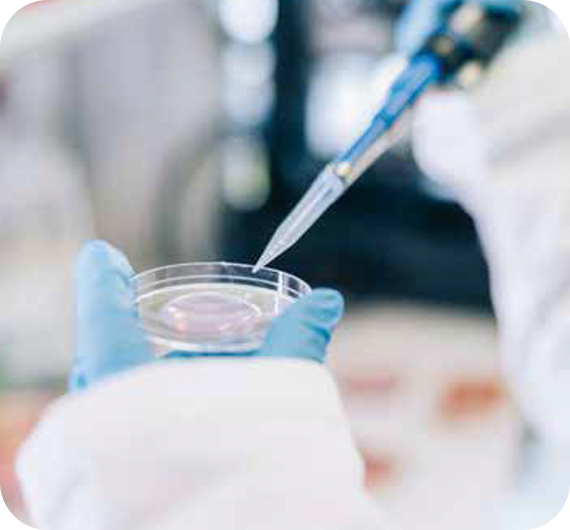

おいしさと感動で、
食文化と社会に貢献。
私たちは、安全・安心でおいしく、お客様に愛される商品とサービスによって
健康で豊かな食生活・日々の感動を提供します。
そして、ライフスタイルや環境に寄りそった食文化と、活気ある未来の社会に貢献していきます。
「いつも、ずっと、お客様に愛され、支持される会社」を目指して。
FOOD SAFETY
食品安全への取り組み
安心・安全をみなさまの食卓へ
R&D